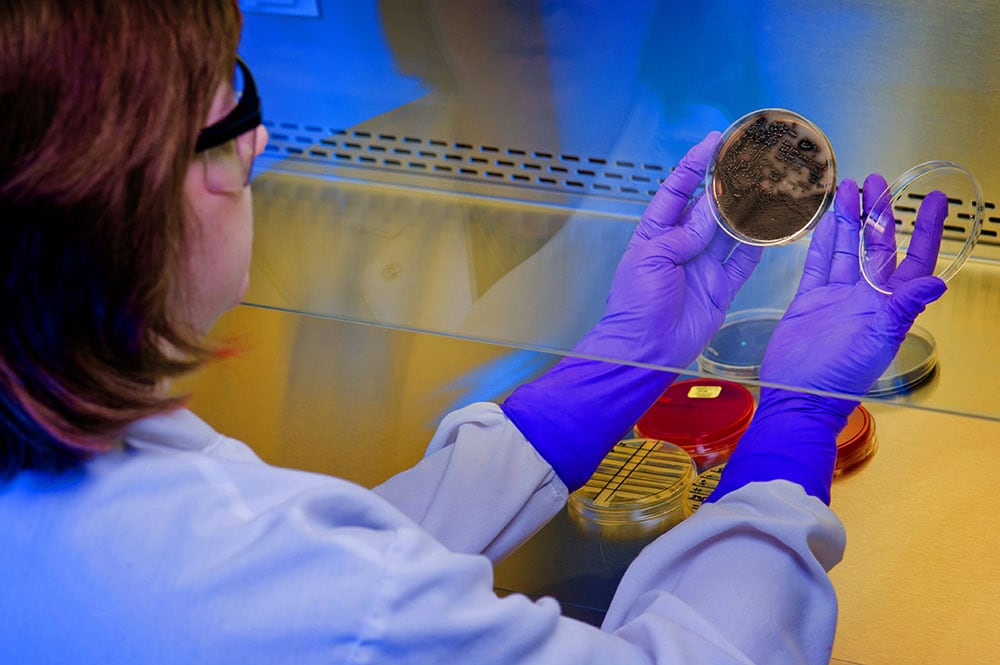
laboratorian.jpg CDC scientist reading a culture plate.

Laboratory Information
CDC’s pertussis and diphtheria laboratorians and epidemiologists can assist health departments during pertussis outbreaks or when a doctor suspects a case of diphtheria.
CDC’s Pertussis and Diphtheria Laboratory provides laboratory support to U.S. health departments requesting assistance with isolation, identification, and sub-typing of
- Bordetella pertussis
- B. parapertussis
- B. holmesii
- B. bronchiseptica
- Corynebacterium diphtheriae
- C. ulcerans
- C. pseudotuberculosis
The laboratory serves as a resource and outbreak support for state and local health departments, domestic and international researchers, and other laboratory and hospital personnel. CDC is also actively involved with developing, evaluating, implementing, and improving molecular and serologic methods, techniques, and strategies. These efforts will enhance the diagnosis and surveillance of agents causing pertussis or diphtheria.
CDC actively participates in international capacity building and consultation for both pertussis and diphtheria diagnostics. In addition to reference activities, the laboratory is involved with domestic and international collaborative research projects that have direct public health relevance.
Confirming B. pertussis in the lab can be difficult and contributes to under-reporting of the disease. Problematic testing for B. pertussis can compromise prevention programs, surveillance activities, vaccine effectiveness studies, and outbreak management.
CDC is researching methods to improve laboratory testing capabilities for B. pertussis. CDC is actively researching new laboratory methods to better identify and characterize other Bordetella and Corynebacterium species.
The Pertussis and Diphtheria Laboratory can offer advice concerning laboratory procedures dealing with bacterial agents that cause pertussis and diphtheria such as
- Isolation and identification of Bordetella and Corynebacterium organisms from clinical specimens
- Detection of organisms by polymerase chain reaction (PCR)
- Testing serum for IgG antibodies to pertussis toxin
Supporting outbreaks and other public health concerns
CDC also performs characterization of B. pertussis isolates by molecular sub-typing, vaccine immunogens deficiency, and whole genome sequencing methods for outbreak support and other public health concerns. Upon request, the laboratory can test for the presence of diphtheria toxin by the Elek assay for C. diphtheriae and C. ulcerans isolates. CDC maintains extensive culture collections that span several years and geographical locations.
CDC will provide laboratory testing only upon prior communication with the Pertussis and Diphtheria Laboratory indicating the reason for this service. If there is a pertussis outbreak or suspected diphtheria case that requires assistance, please call the number listed below.
Pertussis outbreak
If there is a pertussis outbreak that requires assistance or you have questions that your local health department cannot answer, contact CDC. Call 1-800-CDC-INFO or submit a request online to be put in touch with the Meningitis and Vaccine Preventable Diseases Branch.
Diphtheria case
If there is a suspected diphtheria case that requires assistance, please call CDC’s Emergency Operations Center at 770-488-7100.
The Manual for the Surveillance of Vaccine-Preventable Diseases provides current guidelines for those directly involved in surveillance of vaccine-preventable diseases, especially personnel at local health departments. This manual also provides information about specimen collection and shipping.